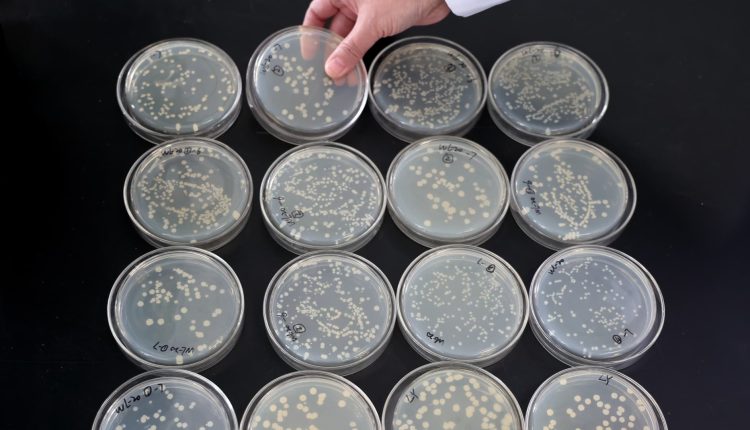
This consumer microbiome startup is betting profits on an AI tool

A probiotic culture experiment in a laboratory.
Future publishing | Future publishing | Getty Images
Seed Health has been pursuing scientific breakthroughs in the microbiome space since its founding in 2015, but its biggest success to date may have been becoming profitable as a life sciences startup. The popularity of the Company's original product, DS-01, a daily probiotic and prebiotic supplement, and its pediatric equivalent, sold directly to consumers through a subscription model in sleek green containers with a 30-day supply, now allows the Company to to invest in this product pioneering science related to probiotics and human and environmental health.
“We are one of the few biotech companies that can claim to be profitable, and one of the great things about profitability is that you can reinvest in future innovations and breakthrough science,” said Ara Katz, co-founder of Seed Health was named to the inaugural CNBC Changemakers list earlier this year.
On Thursday, Seed Health launched CODA, a computational biology platform funded by the profitability of its consumer business. “I always thought about developing a sustainable business model that would allow us to continue doing pioneering science,” Katz said.
The company's SeedLabs division also focuses on environmental applications for bacteria and the microbiome, such as probiotics for corals and honeybees, bacteria to decompose plastic, and the use of volcanic bacteria in carbon capture.
Offering subscriptions to consumer products in one-, three- or six-month increments has helped enable the company to bet on riskier scientific discoveries.
Katz said a benefit of the company's revenue-generating subscription model is greater flexibility and understanding of financial decision-making, “and really ensuring that we can make these investments for the longer term.” For us, “throughput is always about thinking about frontier science that we can accelerate the translation into practice,” she added.
Seed Health co-founders and co-CEOs Ara Katz and Raja Dhir.
Seed health
At its core, CODA is a computational tool that uses AI to process massive amounts of phenotypic and genomic data from the Human Phenotype Project, a massive collection of human data points spanning several decades.
Advised by top researchers such as Eran Segal of the Weizmann Institute of Science and Eric Topol of the Scripps Research Institute, the Human Phenotype Project has a global sample of over 11,000 participants – and a goal of reaching 100,000 participants – conducted annually over a period of 25 months years and includes several biological measures, from the genome, proteome, transcriptome to the microbiome.
Raja Dhir, Katz's co-founder and co-CEO at Seed Health, said CODA and its associated dataset will help standardize microbiome science methods, which has long been a problem in the field. Previous studies have drawn conclusions based on smaller sample sizes, using sampling, analysis and storage methods that are not standardized across the industry.
“What is healthy control? You can't just take any person and assume that they are healthy or not healthy. But when you have 10,000 people and all this data about them … we compare our least healthy people to that.” “To support our healthiest people and develop a lot more tools,” said Dhir, who leads Seed Health's environmental research and about Has expertise in translating scientific research into product innovations.
As an example, Dhir pointed to a study of 500 people that might conclude that the presence of a particular bacterium predicts weight gain, for example, but another study of another 500 people by a different organization or institution might reach a completely different conclusion Diploma. According to Dhir, CODA's large sample size and numerous data points offer the potential for standardization that has not yet been achieved.
“We saw that the whole field of probiotics and certainly so much of the obsession with gut health didn't really reflect the scientific approach that we really thought we really wanted to pursue and push forward,” Katz added.
Independent experts in the field agree that the science needs to improve. “I see a lot of probiotics out there, everyone is jumping on the probiotic bandwagon, like you see probiotic drinks and probiotic foods, and I'm like: Really? Does it really work? And that's frustrating to me as a scientist and someone who wants to improve health. So I think it's going to be really important to increase the scientific rigor and testing and do these clinical trials,” said Dr. Arpana Gupta, associate professor at UCLA and co-director of the Goodman-Luskin Microbiome Center. “That’s definitely promising.”
The initial applications of CODA are in the areas of metabolic health, brain health, longevity and menopause. These research areas were chosen because they had already been identified as areas of human health where early CODA data provided the strongest evidence.
“I take these insights [from CODA]I think that would be the biggest contribution and that's what excites me, because then without CODA all of these findings might end up very nicely and eventually translated and made available to the billions of people who could benefit from papers, but just papers. And that’s how they can eventually be transmitted to humans,” said Segal, who has studied metabolic health and the connection between the microbiome and body composition.
Segal said the Human Phenotype Project included the collection of dietary logs and medical histories, as well as glucose monitoring records and DEXA (bone densitometry) scans, much of which spanned two decades and provided insights into the changing and aging human microbiome.
“It's a huge step forward not only in the standardization of data, but also in the different types of data. That’s why it’s called deep phenotyping, because phenotyping means all of these things coming together to make a person’s phenotype,” Dhir said. “That’s what CODA unlocks. … There are things that were previously just lost in the noise, in the noise of bioinformatics data, that are now emerging in such clear signals.”
Seed Health has worked on several projects pioneering microbiome science for human and planetary health.
Many in the field believe the approach will have broader applications.
“I think the top areas right now are in cancer,” said Dr. Joseph Petrosino, professor at Baylor College of Medicine and director of the Center for Metagenomics and Microbiome Research and member of the Seed Health Scientific Advisory Board. “The ability to use the microbiome as both a diagnostic and a potential therapeutic to support response to various cancer treatments and avoid some of the side effects of these treatments,” Petrosino said.
Seed Health says it has no current plans to use CODA for cancer-related research.

Comments are closed.